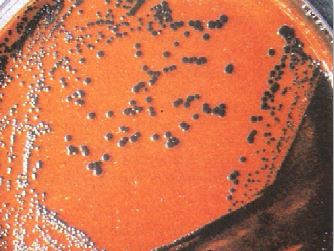

النبات

مواضيع عامة في علم النبات

الجذور - السيقان - الأوراق

النباتات الوعائية واللاوعائية

البذور (مغطاة البذور - عاريات البذور)

الطحالب

النباتات الطبية


الحيوان

مواضيع عامة في علم الحيوان

علم التشريح

التنوع الإحيائي

البايلوجيا الخلوية


الأحياء المجهرية

البكتيريا

الفطريات

الطفيليات

الفايروسات


علم الأمراض

الاورام

الامراض الوراثية

الامراض المناعية

الامراض المدارية

اضطرابات الدورة الدموية

مواضيع عامة في علم الامراض

الحشرات


التقانة الإحيائية

مواضيع عامة في التقانة الإحيائية


التقنية الحيوية المكروبية

التقنية الحيوية والميكروبات

الفعاليات الحيوية

وراثة الاحياء المجهرية

تصنيف الاحياء المجهرية

الاحياء المجهرية في الطبيعة

أيض الاجهاد

التقنية الحيوية والبيئة

التقنية الحيوية والطب

التقنية الحيوية والزراعة

التقنية الحيوية والصناعة

التقنية الحيوية والطاقة

البحار والطحالب الصغيرة

عزل البروتين

هندسة الجينات


التقنية الحياتية النانوية

مفاهيم التقنية الحيوية النانوية

التراكيب النانوية والمجاهر المستخدمة في رؤيتها

تصنيع وتخليق المواد النانوية

تطبيقات التقنية النانوية والحيوية النانوية

الرقائق والمتحسسات الحيوية

المصفوفات المجهرية وحاسوب الدنا

اللقاحات

البيئة والتلوث


علم الأجنة

اعضاء التكاثر وتشكل الاعراس

الاخصاب

التشطر

العصيبة وتشكل الجسيدات

تشكل اللواحق الجنينية

تكون المعيدة وظهور الطبقات الجنينية

مقدمة لعلم الاجنة


الأحياء الجزيئي

مواضيع عامة في الاحياء الجزيئي


علم وظائف الأعضاء


الغدد

مواضيع عامة في الغدد

الغدد الصم و هرموناتها

الجسم تحت السريري

الغدة النخامية

الغدة الكظرية

الغدة التناسلية

الغدة الدرقية والجار الدرقية

الغدة البنكرياسية

الغدة الصنوبرية

مواضيع عامة في علم وظائف الاعضاء

الخلية الحيوانية

الجهاز العصبي

أعضاء الحس

الجهاز العضلي

السوائل الجسمية

الجهاز الدوري والليمف

الجهاز التنفسي

الجهاز الهضمي

الجهاز البولي


المضادات الميكروبية

مواضيع عامة في المضادات الميكروبية

مضادات البكتيريا

مضادات الفطريات

مضادات الطفيليات

مضادات الفايروسات

علم الخلية

الوراثة

الأحياء العامة

المناعة

التحليلات المرضية

الكيمياء الحيوية

مواضيع متنوعة أخرى

الانزيمات
الحالات المرضية البكتيرية : الحالة الحادية والعشرون
المؤلف:
عبد الرزاق سليمان التومي ، محمد محمد الامام ، عبد الباسط رمضان
المصدر:
اساسيات التشخيص البكتريولوجي المعملي والسريري
الجزء والصفحة:
1-9-2016
1847
الحالات المرضية البكتيرية : الحالة الحادية والعشرون
محامي وصل منذ ثلاثة أيام من السفر أحضر إلى قسم الطوارئ وهو يعاني من تقرح الحلق sore throat و orodynia ، صداع مع فشل عام، كما يعاني من ارتفاع في درجة الحرارة ونوبات تسرع ضربات القلم tachycardia . بفحص البلعوم لوحظ وجود غشاء ملتصق على الحلقوم. اخذت مسحة وأرسلت إلى مختبر التحليل الجرثومي لفحصها مجهرياً كما في الشكل رقم 1 وزراعتها على وسط غذائي مناسب كما في الشكل رقم 2 . تم إجراء الاختبار المعملي كما في الشكل رقم 3 .

الشكل رقم 1 : الفحص المجهري
الشكل رقم 2 المزرعة البكتيرية

الشكل رقم 3 الاختبار المعملي
الأسئلة :
1- ما هي المضاعفات التي قد تلي هذه الإصابة ؟ وكيف يتم حدوث هذا المرض؟
2- كيف يتم التأكد من هذا التشخيص معملياً ؟ وما اسم الاختبار الموجود في الشكل رقم 3 ؟
3- كيف يمكن الوقاية من هذا المرض؟ وكيف سيتم التعامل مع هذا المريض؟
الإجابة :
1- التشخيص السريري لهذا المريض هو اصابته بمرض الخناق diphtheria وهذا المرض تسببه سلالات من النوع البكتيري Corynebacterium dipheriae منتجة للذيفان ، وقد يكون نتيجة الإصابة بأنواع أخرى من هذه البكتيريا المنتجة للذيفان مثل النوع البكتيري C. ulcerans حيث تصاب هذه البكتيريا بالفيروس الذي يحمل شفرة تصنيع الذيفان فتصبح البكتيريا منتجة للذيفان. وعادة ما تنتقل العدوى عن طريق رذاذ الأعراض، وهذه الأعراض تظهر نتيجة إصابة الجهاز التنفسي العلوي بالبكتيريا الممرضة فنجدها في البلعوم الأنفي والحلقوم والحنجرة ويتصف هذا المرض يتكون غشاء ملتصق . وقد أعراض بدون وجود دليل على إصابة الخيشوم nasophaeyngeal وقد تكون الإصابة بمرض الخناق نتيجة الإصابة الخيشوم nasophayngeal وقد تكون الإصابة بمرض الخناق نتيجة الإصابة الجلدية بجراثيم بكتيرية منتجة للذيفان وهذا غالباً ما يكون في المناطق الاستوائية.
سلالات النوع البكتيري C. diphtheria المصابة بالفيروس (B-bacteriophage) تنتج ذيفان خارجي exotoxins ينتشر في الدم وهذا الذيفان يتكون من وحدتين أحداهما يرتبط بمستقبل متواجد على الخلية فيسهل دخول الوحدة الثاني إلى سيتوبلازم الخلية مما يؤدي في نهاية الأمر إلى توقف تصنيع البروتين في الخلية المصابة.
2- يتم التاكد من التشخيص بأخذ مسحة من الحلق والأنف لفحصها مجهرياً وزراعتها على الوسط الغذائي المناسب وهو الوسط الغذائي Hoyle's أو الوسط الغذائي Tindsale's medium وهما وسط غذائي انتقائي وتفريقي.
وكذلك الوسط الغذائي المغذي Loeffler's agar المائل ويتم التعرف على البكتيريا المعزولة بإجراء الاختبارات الكيموحيوية ويكشف على الذيفان بطريقة Elek's كما في الشكل رقم 3 ، حيث يجري هذا الاختبار بغمر ورقة الترشيح في مضاد الذيفان ثم وضعها على الطبق المحتوي على الوسط الغذائي المناسب ، بعد ذلك تزرع البكتيريا قيد الاختبار على الطبق مع زرع بكتيريا سالبة وأخرى موجبة لهذا الاختبار على الطبق مع زرع بكتيريا سالبة وأخرى موجبة لهذا الاختبار للتأكد من صحة النتائج المتحصل عليها، إلا أنه من الأفضل استعمال تقنية التفاعل التسلسلي للبوليمرات (PCR) للكشف عن السلالات المنتجة للذيفان.
3- بمجرد أن يتم التشخيص السرسري للحالة على أنها مرض الخناق تؤخذ عينة من الحلق والأأنف ويحال المريض إلى قسم الأمراض السارية لإيوائه في حجرة معزولة مع إعطاء المريض مضاد للذيفان والمضاد الحيوي erythromycin كما يتم إبلاغ المختصين في الأمراض السارية على الفور وإعداد قائمة بكل الأشخاص المحيطين بهذا المريض بما في ذلك الطاقم الطبي الذي كشف على المريض وزملائه في العمل لتؤخذ منهم مسحة من الأنف والحلق وإعطائهم المضاد الحيوي erythromycin كإجراء وقائي. الأشخاص غير المرضى والحاملين للنوع البكتيري C. diphtheria المنتج للذيفان والحالات الأخرى المصابة يتم عزلهم وعلاجهم بنفس الطريقة التي تم بها علاج الحالة المعدية. من الممكن منع حدوث هذا المرض بالتحصين وذلك باستعمال شبيه الذيفان toxoid وهو يعطي في الأشهر الاولى من العمر.
 الاكثر قراءة في البكتيريا
الاكثر قراءة في البكتيريا
 اخر الاخبار
اخر الاخبار
اخبار العتبة العباسية المقدسة

الآخبار الصحية















 قسم الشؤون الفكرية يصدر كتاباً يوثق تاريخ السدانة في العتبة العباسية المقدسة
قسم الشؤون الفكرية يصدر كتاباً يوثق تاريخ السدانة في العتبة العباسية المقدسة "المهمة".. إصدار قصصي يوثّق القصص الفائزة في مسابقة فتوى الدفاع المقدسة للقصة القصيرة
"المهمة".. إصدار قصصي يوثّق القصص الفائزة في مسابقة فتوى الدفاع المقدسة للقصة القصيرة (نوافذ).. إصدار أدبي يوثق القصص الفائزة في مسابقة الإمام العسكري (عليه السلام)
(نوافذ).. إصدار أدبي يوثق القصص الفائزة في مسابقة الإمام العسكري (عليه السلام)


















